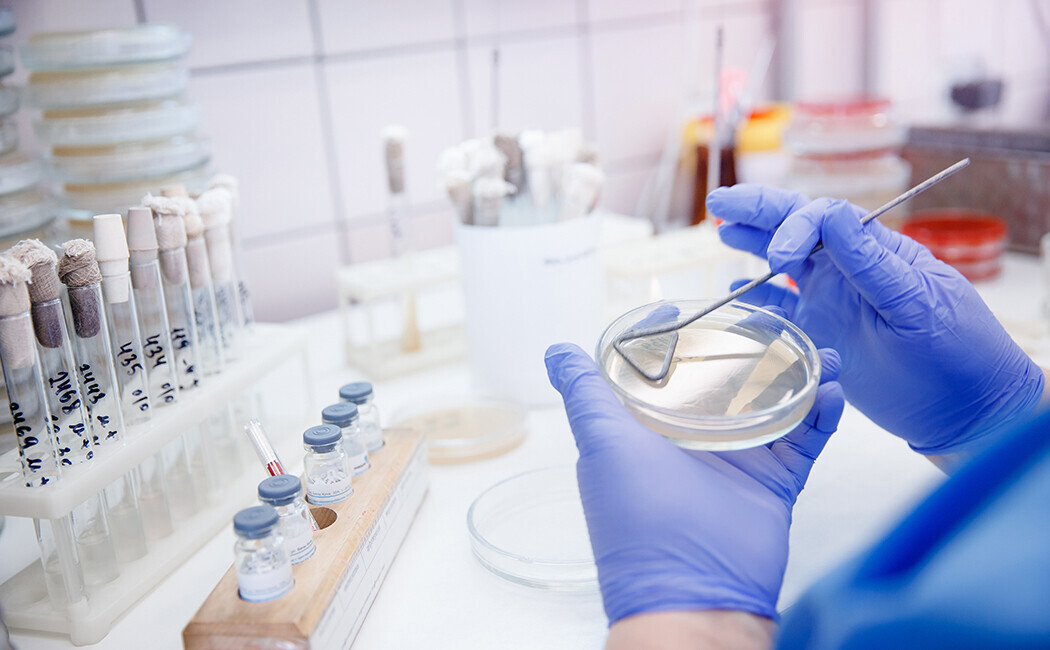

Бак посев мочи — что это за анализ, как правильно сдавать, сколько делается
Бактериальные инфекции органов выделительной системы — распространенная причина обращения пациентов к урологу. Они проявляются резью во время мочеиспускания, повышением температуры тела, частыми позывами к выделению мочи, болью в промежности, слабостью и другими симптомами. Для назначения медикаментозной терапии и других методов лечения нужно идентифицировать возбудителя инфекции. Бак (бактериальный) посев мочи на микрофлору — эффективный метод диагностики таких заболеваний. Он также назначается при обследовании по поводу инфекций других органов и систем.

- Что это за анализ?
- Диагностика инфекций органов выделения
- Что показывает бак посев мочи?
- Как правильно сдавать?
- Результаты бак посева мочи
- Сколько времени делается?
Что это за анализ?
Бактериальный посев мочи — метод лабораторной диагностики, позволяющий выявить в моче вызывающие инфекционный процесс в органах выделительной системы бактериальные клетки. Подобные заболевания могут развиваться из-за деятельности патогенных или условно-патогенных агентов. Патогенные бактерии попадают в органы выделительной системы извне при несоблюдении личной гигиены и незащищенном половом акте. Условно-патогенные микроорганизмы уже присутствуют в тканях, но не вызывают болезнь в норме, поскольку иммунитет их сдерживает. При возникновении благоприятных для них факторов возникает инфекционный процесс.

Диагностика инфекций органов выделения
Стрептококки, стафилококки и другие патогены часто поражают различные органы выделительной системы, включая мочевой пузырь и уретру. При восходящем типе заболевания бактериальные клетки из мочеиспускательного канала распространяются в мочевой пузырь, мочеточники и почечную ткань. Возникает серьезное осложнение. Реже наблюдается нисходящая инфекция, когда бактерии из почек попадают в нижние отделы выделительной системы.
Подобные патологии в большей степени характерны для женщин. Короткая уретра у девушек — фактор риска попадания патогенов в организм из внешней среды, включая анальное отверстие. Присутствующие в кишечнике микроорганизмы в норме не вызывают патологическое состояние, но после миграции в мочевыделительную систему становятся причиной ее инфицирования. Вынашивание ребенка — дополнительный фактор риска, поскольку организм подвергается эндокринным и анатомическим преобразованиям. Часто у беременных женщин цистит не вызывает симптомов, но обуславливает осложнения, вроде ранних родов.
У пациентов в преклонном возрасте чаще возникают подобные болезни из-за снижения иммунитета. Различные медицинские процедуры тоже повышают вероятность инфицирования тканей. Например, при катетеризации мочеиспускательного канала в больнице в организм могут попасть бактериальные клетки. Особенно опасны устойчивые к лечению внутрибольничные штаммы.

Что показывает бак посев мочи?
Полученную биологическую жидкость проверяют на предмет присутствия микроорганизмов, вызывающих патологический процесс. Бактериальный посев мочи подходит для выявления грибковых и бактериальных угроз. При этом врачи понимают, что эта среда никогда не бывает стерильной. В материале будут присутствовать нейтральные микроорганизмы, вроде лактобацилл, не учитываемые в диагностике. При обнаружении характерных симптомов специалисты ищут Candida spp, Proteus spp., Staphylococcus saprophyticus и других патогены, деятельность которых ассоциирована с поражением выделительной системы.
Бак посев мочи на микрофлору помогает специалисту получить точные клинические сведения и поставить диагноз. Выполняется идентификация микроорганизма для уточнения типа инфекционного процесса. В целях повышения эффективности лечения выращенные на питательных средах бактерии или грибки подвергаются действию разных антибиотиков и противогрибковых средств. Так врач выбирает наиболее эффективный способ терапии.
Обнаруживаемые заболевания:
- инфекция мочевого пузыря (цистит), проявляющаяся болезненностью в области промежности и лобка, частыми позывами к мочеиспусканию, резью и другими симптомами;
- пиелонефрит или инфекция почечной ткани, при которой пациент жалуется на повышение температуры тела, частое выделение мочи, боли в поясничной области;
- инфекция мочеиспускательного канала, сопровождающаяся резью, частыми позывами к выделению мочи, лихорадкой.

Бак посев мочи на микрофлору при пиелонефрите важен, поскольку его несвоевременное или неправильное лечение может стать причиной острого нарушения работы органа и перехода инфекции в септическую форму. При хронических инфекциях комплексная диагностика, включающая бактериальный посев, дает возможность улучшить качество жизни пациента. Также этот метод часто назначают при беременности в целях предотвращения развития инфекционных осложнений. Мужчинам это исследование требуется для диагностики воспаления предстательной железы.
Как правильно сдавать?
Высокая точность диагностики достигается только при соблюдении всех рекомендаций врача, связанных с правилами подготовки. Следует исключить проникновение в жидкость микроорганизмов извне. Материал транспортируют в одноразовом стерильном контейнере. Перед мочеиспусканием нужно как следует подмыться и удалить любые загрязнения, которые могут попасть в жидкость. Не следует переливать жидкость в другой контейнер. Если диагностика проводится во время менструации, следует воспользоваться тампоном. За 2-3 дня до исследования нужно исключить употребление алкоголя, сдобы на основе дрожжей. По рекомендации врача нужно прекратить прием определенных лекарств.

Забор мочи производится после пробуждения. Перед этим минимум в течение 4 часов пациент не должен употреблять пищу или ходить в туалет. В первые пару секунд мочеиспускание производится в унитаз и только после этого начинается наполнение контейнера. Нужно получить примерно 50 миллилитров жидкости. По показаниям процедура проводится в более поздние часы или с применением катетеризации, если пациент не может помочиться самостоятельно. Материалы направляют в лабораторию не позже полутора часов после их сбора. В холодильнике мочу можно хранить в закрытой емкости не дольше 6 часов.
Результаты бак посева мочи
Получение клинической информации проводится через двое суток инкубационного периода. Правильно оценить результаты может только врач, назначивший исследование.
Расшифровка:
- уровень микроорганизмов меньше тысячи КОЕ на миллилитр — отрицательный результат;
- уровень бактериальных клеток более ста тысяч КОЕ на миллилитр — положительный результат.
Врач оценивает результат с учетом общих жалоб, анамнестических данных, полученных с помощью других обследований сведений.
Сколько времени делается?
В большинстве случаев время ожидания результатов после доставки материала составляет от 4 до 7 суток. В некоторых клиниках доступен экспресс-тест, позволяющий получить данные уже через 2 дня. Если обследуют пациента в тяжелом состоянии, когда требуется быстрое проведение лечения, результаты можно получить в течение суток. Время ожидания зависит от специфики работы клиники.